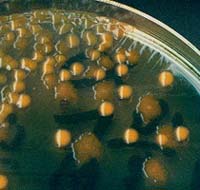
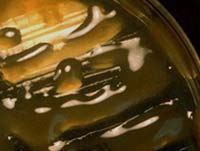
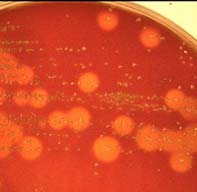

| Objectifs : Connaître les principaux éléments de la physiologie bactérienne : croissance bactérienne, mode respiratoire, et application à l'identification bactérienne. |
A - DIVISION BACTERIENNE
La bactérie se multiplie par fission binaire : la bactérie grandit puis se divise en deux cellules filles séparées par un septum de division formé par la paroi cellulaire. Durant la division, l'ADN se duplique ainsi que les autres constituants. Divers systèmes enzymatiques de synthèse et de dégradation participent à la division cellulaire.

B - DYNAMIQUE DE LA CROISSANCE
La croissance bactérienne est l'accroissement ordonné de tous les composants de la bactérie. Elle aboutit à l'augmentation du nombre de bactéries.
Au cours de la croissance, il se produit, d'une part, un appauvrissement du milieu de culture en nutriments et, d'autre part, un enrichissement en sous-produits du métabolisme, éventuellement toxiques. La croissance peut être étudiée en milieu liquide ou solide.
1 - Courbe de croissance : La croissance d'une bactérie s'étudie en milieu liquide. Il existe 6 phases dont l'ensemble constitue la courbe de croissance.
. Phase de latence : le taux de croissance nul (µ = 0). La durée de cette phase dépend de l'âge des bactéries et de la composition du milieu. C'est le temps nécessaire à la bactérie pour synthétiser les enzymes adaptées au nouveau substrat (pas de phase de latence si repiquage sur milieu identique au précédent).
. Phase d'accélération : il se produit une augmentation de la vitesse de croissance.
. Croissance exponentielle : le taux de croissance atteint un maximum (µ=max). Cette phase dure tant que la vitesse de croissance est constante. Le temps de doublement des bactéries est le plus court. La masse cellulaire est représentée par des cellules viables (mortalité nulle).
. Phase de ralentissement : la vitesse de croissance régresse. Il y a un épuisement du milieu de culture et une accumulation des déchets. Il existe un début d'autolyse des bactéries.
. Phase maximale stationnaire : le taux de croissance devient nu (µ = 0). Les bactéries qui se multiplient compensent celles qui meurent.
. Phase de déclin : le taux de croissance est négatif (µ < 0). Toutes les ressources nutritives sont épuisées. Il y a accumulation de métabolites toxiques. Il se produit une diminution d'organismes viables et une lyse cellulaire sous l'action des enzymes protéolytiques endogènes. Cependant, il persiste une croissance par libération de substances libérées lors de la lyse (croissance cryptique).
Exemple d'une courbe de croissance
 |
1 : phase de latence,
2 : phase de croissance exponentielle, 3 : phase de ralentissement, 4 : phase stationnaire, 5 : phase de déclin. |
Courbe de croissance dans un automate d'hémoculture
 |
 |
2 - Croissance in vitro (milieux liquides et solides)
Les bactéries peuvent être cultivées en milieux liquide, solide et semi-liquide. Les milieux liquides sont utilisés pour la culture de bactéries pures ou lors d'infection monomicrobienne (hémoculture).
Exemples : culture d'une bactérie dans un bouillon nutritif ou encore à partir du sang d'un malade (hémoculture en flacon)
 |
 |
Les milieux solides ou semi-solides, à base d'agar (gélose), sont utilisés pour l'isolement de bactéries. Dans ces milieux, ont été ajoutés des nutriments favorisants la croissance des bactéries étudiées.
Exemples : culture par isolement d'une bactérie à la surface d'un milieu gélosé contenant du sang (mouton, cheval) montrant après 18 à 24 H à 37°C d'incubation des colonies hémolytiques.
 |
 |
3 - Croissance in vivo
In vivo, la croissance bactérienne n'est pas similaire à celle observée in vitro. Elle est beaucoup plus ralentie. La phase de latence est beaucoup plus longue. Les bactéries n'ont pas toujours tous les nutriments à leur disposition pour leur croissance. In vivo, les bactéries peuvent être phagocytées par les macrophages et les polynucléaires et être inhibées par les produits antibactériens comme le lysozyme ou le complément.

4 - Croissance en culture continue
Il y a maintien d'une croissance exponentielle continue lorsque le milieu de culture est renouvelé régulièrement et que les métabolites sont éliminés en même temps. La valeur µ est maximale et constante.
5 - Croissance en culture synchrone
Les bactéries se multiplient toutes au même moment. La courbe de croissance montre des paliers successifs. Ce type de culture permet d'étudier la division cellulaire indépendamment de la croissance.
6 - Croissance en biofilm
Les bactéries peuvent s'attacher aux surfaces, s'associer entre elles et s'entourer d'un polymère organique pour constituer un biofilm. Leur organisation et leur métabolisme dépendent de la nature de la surface et de l'environnement physico-chimique. Les biofilms intéressent tous les domaines de la microbiologie et de la médecine (matériels d'exploration, matériels implantés, muqueuses lésées). Les biofilms sont caractérisés par une hétérogénéité spatiale : il existe des variations métaboliques importantes à l'intérieur du biofilm et à l'interface milieu liquide/milieu solide.
Schéma d'organisation d'un biofilm

|
7 - Effets de carence et de stress
En situation de carence ou de stress, la bactérie peut adopter deux types de stratégie pour sa survie : 1 - la bactérie se différencie vers une forme de résistance métaboliquement inactive C'est le cas des Bacillus qui produisent une spore. 2 - la bactérie développe des systèmes de régulation pour contrôler cette période de carence en adaptant son métabolisme pour faire un maximum d'économie. C'est le cas de Escherichia coli. Dans ce type de situation, la bactérie présente les adaptations suivantes : |
 |
. Dégradation des protéines : libération d'acides aminés réutilisés ou dégradés pour la production d'énergie
. Mise en œuvre de systèmes de transport et d'assimilation comme substituts aux éléments manquants qui sont essentiellement les composés azotés, phosphorés, carbonés et le fer.
. Synthèse de protéines de stress qui protègent la bactérie de la privation de nutriments et d'autres stress (existence de gènes impliqués dans les phénomènes de carence ou de stress).
C - CONDITIONS FAVORABLES A LA CROISSANCE
1 - Sources d'énergie
Les bactéries doivent trouver dans leur environnement les substances nécessaires à leur énergie et à leurs synthèses cellulaires.
Les bactéries phototrophes utilisent l'énergie lumineuse pour la photosynthèse (synthèse d'ATP à partir d'ADP et de phosphate inorganique).
Les bactéries chimiotrophes puisent leur énergie à partir de composés minéraux ou organiques. Elles utilisent des donneurs et des accepteurs d'électrons (élément minéral : bactérie chimiolithotrophe ; élément organique : bactérie chimioorganotrophe).
La grande majorité des bactéries d'intérêt médical sont chimioorganotrophes.
2 -Sources de carbone
Le carbone est l'un des éléments les plus abondants de la bactérie. Le plus simple des composés est l'anhydride carbonique ou CO2. Celui-ci peut être utilisé par la bactérie pour la synthèse de certains métabolites essentiels qui ferait intervenir une réaction de carboxylation.
Le CO2 est la seule source de carbone pour les bactéries autotrophes. Les bactéries hétérotrophes utilisent facultativement le CO2. Les bactéries hétérotrophes dégradent une grande quantité de substances hydrocarbonées (alcool, acide acétique, acide lactique, polysaccharides, sucres divers).
3 - Sources d'azote et besoins en soufre
Les bactéries ont besoin de substances azotées pour synthétiser leurs protéines. La provenance de cet azote peut se faire par fixation directe de l'azote atmosphérique ou par incorporation de composés azotés (réactions de désamination, de transamination)
Le soufre est incorporé par les bactéries sous forme de sulfate ou de composés soufrés organiques.
4 - Besoins inorganiques
Le phosphore fait partie des acides nucléiques et de nombreuses réactions enzymatiques. Il permet la récupération, l'accumulation et la distribution de l'énergie dans la bactérie. Il est incorporé sous forme de phosphate inorganique.
5 - Autres éléments
D'autres éléments jouent un rôle dans le métabolisme bactérien (sodium, potassium, magnésium, chlore) et dans les réactions enzymatiques (calcium, fer, magnésium, manganèse, nickel, sélénium, cuivre, cobalt, vitamines)
|
Exemple d'un milieu solide minimum pour étudier le transfert de marqueurs d'auxotrophie (cf découverte de la conjugaison)
composition: SO4(NH2)2 1 g, PO4K2H 7g, PO4KH2 2g, citrate 0,5g, SO4Mg, 7H2O 1g, eau 500 ml |
 |
D - CONDITIONS PHYSICO-CHIMIQUES DE LA CROISSANCE
1 - Effet de l'oxygène
Il existe plusieurs classes de bactéries en fonction de leurs rapports avec l'oxygène.
|
1 - Les bactéries aérobies strictes ne se développent qu'en présence d'air. Leur source principale d'énergie est la respiration. L'oxygène moléculaire, ultime accepteur d'électron, est réduit en eau (Pseudomonas, Acinetobacter, Neisseria).
2 - Les bactéries microaérophiles se développent mieux ou exclusivement lorsque la pression partielle d'oxygène est inférieure à celle de l'air (Campylobacter, Mycobacteriaceae). 3 - Les bactéries aéro-anaérobies facultatives se développent avec ou sans air. C'est le cas de la majorité des bactéries rencontrées en pathologie médicale : les entérobactéries (Escherichia, Salmonella), les streptocoques, les staphylocoques. L'énergie provient de l'oxydation des substrats et de la voie fermentaire. |
 |
|
4 - Les bactéries anaérobies strictes ne se développent qu'en absence totale ou presque d'oxygène qui est le plus souvent toxique. Ces bactéries doivent se cultiver sous atmosphère réductrice. La totalité de l'énergie est produite par fermentation.
|
 |
Mode d'action de la superoxide dismutase, de la catalase et de la peroxydase

Exemple : Etuve avec culture de bactéries anaérobies stricts en jarre

Autre exemple : culture de bactéries anaérobies stricts en sachet plastique et en atmosphère contrôlée

2 - Effet de la température
Les bactéries peuvent être classées selon leur température optimale de croissance.
- Bactéries mésophiles (Ex. : Escherichia coli) : température de croissance proche de celle du corps humain (37°C)
- Bactéries thermophiles (Ex. : Thermus aquaticus) : températures de croissance comprises entre 45°C et 70°C .
- Bactéries hyperthermophiles (Ex. : Archaea) : températures de croissance supérieures à 80°C .
- Bactéries psychrophiles (Ex. : ) :Températures proches de 0°C (optimum à 10-15°C).
- Bactéries psychrotrophes (Ex. : Pseudomonas) : températures de croissance proches de 0°C avec optimum de croissance proche des bactéries mésophiles.
Exemple : Dans un laboratoire d'analyse, étuve dont la température intérieure est réglée à 37°C
 |
 |
Autre exemple : étuve dont la température intérieure est réglée à 37°C avec une atmosphère de 5% de gaz carbonique (CO2)

3 - Effet du pH
Le pH (concentration en ion hydrogène [H+]) de l'environnement varie entre 0,5 (sols acides) et 10,5 (eaux alcalines des lacs).
Les bactéries pathogènes ou liées à l'écosystème humain se développent le plus souvent dans des milieux neutres ou légèrement alcalins.
On distingue les bactéries:
- neutrophiles qui se développent pour des pH sont compris entre 5,5 et 8,5 avec un optimum voisin de 7. La plupart des bactéries médicalement importantes sont ainsi.
Exemple : isolement d'une souche de Escherichia coli sur un milieu usuel

- alcalophiles qui préfèrent les pH alcalins: cas de Pseudomonas et Vibrio, donc milieux de culture particuliers
- acidophiles qui se multiplient mieux dans des milieux acides : cas des Lactobacillus.
4 - Effet de la pression osmotique
Les bactéries sont assez tolérantes aux variations des concentrations ioniques. Certaines espèces sont osmotolérantes (staphylocoques, Vibrio cholerae).
5 - Effet de l'eau libre
La disponibilité de l'eau présente dans l'atmosphère ou dans une substance intervient dans la croissance bactérienne. L'activité de l'eau (Aw) est inversement proportionnelle à la pression osmotique d'un composé. Ainsi, elle est affectée par la présence plus ou moins importante de sels ou de sucres dissous dans l'eau.
- Présence de sels : Les bactéries halophiles nécessitent du sel (NaCl) pour leur croissance. Cette concentration peut varier de 1-6% pour les faiblement halophiles jusque 15-30% pour les bactéries halophiles extrêmes (Halobacterium).
Les bactéries halotolérantes acceptent des concentrations modérées de sels mais non obligatoires pour leur croissance (Ex. : Staphylococcus aureus).
- Présence de sucres : Les bactéries osmophiles nécessitent des sucres pour leur croissance. Celles osmotolérantes acceptent des concentrations modérées de sucres mais non obligatoires pour leur croissance. Enfin les bactéries xérophiles peuvent se multiplier en l'absence d'eau dans leur environnement.
6 - Métabolisme énergétique
On peut opposer les bactéries ayant un métabolisme fermentatif et celles ayant un métabolisme de type respiratoire.
Pour les bactéries à métabolisme fermentatif, la dégradation du glucose est incomplète et aboutit à la formation de divers composés organiques (acides organiques).
Pour les bactéries ayant un métabolisme oxydatif , la dégradation se fait par le cycle de Krebs. L'accepteur final d'électron est l'oxygène. Chez les bactéries, le système de transport d'électrons est situé dans la membrane cytoplasmique.
Exemple : Mise en évidence du caractère fermentaire (A) ou oxydatif (B) avec un milieu dit de MEVAG contenant du glucose. Le témoin (C) est le même milieu sans sucre ensemencé de manière identique.


E - APPLICATIONS
1 - Milieux de culture
Un milieu de culture est composé d'un mélange de substrats nutritifs (acides aminés, peptides, bases nucléiques, sucres, etc), d'un système tampon pour éviter les variations importantes du pH, de sels minéraux et de vitamines. Il est possible d'ajouter d'autres facteurs de croissance (sang, protéines, hémoglobine, vitamines). Ils sont de nature solide, semi-solide ou liquide.
Parmi les milieux de culture, on distingue les milieux :
- d'isolement qui sont le plus souvent solides (gélosés) et de composition variable pour permettre le développement de plusieurs espèces bactériennes: gélose au sang frais, gélose dite au sang cuit…….
Exemple : isolement d'une aspiration bronchique sur milieu gélosé au sang frais (A), au sang cuit (B) ou contenant des substrats chromogéniques (C)



- sélectifs qui favorisent artificiellement la croissance d'une espèce au détriment des autres tels le Milieu de Chapman (hypersalé + mannitol + indicateur de pH), Drigalski (sels biliaires + cristal violet + lactose + indicateur de pH)………
Exemple : culture d'une part sur le milieu de Chapman (gauche) de trois souches de Staphylococcus aureus et d'autre part sur celui de Drigalski (droite) de Escherichia coli et Proteus mirabilis


- identification permettent au cours de l'isolement ou non de mettre en évidence une ou plusieurs propriétés biochimiques d'une bactérie pour commencer à l'identifier

2 - Apparences des colonies
L'aspect des colonies est le caractère primaire utilisé pour orienter le diagnostic effectué par le bactériologiste. La forme des colonies dépend de :
| A) facteurs intrinsèques à la bactérie : mobilité, morphologie : taille, forme, contour, relief, surface production d'une capsule, production de matériel extracellulaire, pigmentation, présence de fimbriae B) facteurs extrinsèques : gradients de solutés créés autour de la colonie présence de colorants dans le milieu de culture. |
Exemple : Aspects de colonies bactériennes sur le milieu sélectif dénommé Drigalski
|
 |
|
 |
Autre exemple : Aspects de colonies bactériennes sur le milieu enrichi au sang

3 - Recherche des caractères biochimiques
L'identification des bactéries est effectuée en utilisant des milieux de culture dont la composition permet de mettre en évidence une enzymatique.
Exemples : activités variables (souches A et B) de type ß-galactosidase (ONPG), lysine décarboxylase (LDC), ornithine décarboxylase (ODC), uréase (URE) .........


L'activité fermentaire est révélé avec un milieu type contenant un sucre, un indicateur coloré des changements de pH. La fermentation du sucre entraîne un abaissement du pH et donc un changement de couleur de l'indicateur coloré.
Exemples : activité fermentaire positive vis-à-vis de divers hydrates de carbone:


A l'heure actuelle, des systèmes automatisés plus sensibles effectuent des mesures photométriques en continu et peuvent identifier les principales bactéries isolées en pratique médicale en moins de 5 heures.
Exemples : automates d'identification et de sensibilité aux antibiotiques



Ce cours a été préparé par le Professeur R. Courcol (Faculté de Médecine- Université Lille 2)
|
|
|
|
|